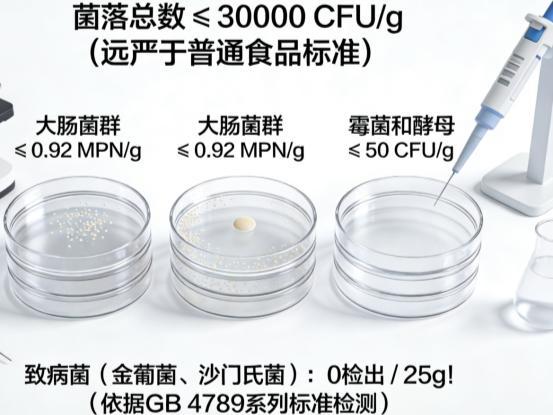
2026 乳清蛋白粉成分检测权威发布：国内优质乳清蛋白粉品牌有哪些？好物全收录(图4)

2026 乳清蛋白粉成分检测权威发布:国内优质乳清蛋白粉品牌有哪些?好物全收录
九游体育官方网站“蛋白粉=增肌粉?”——这恐怕是健身圈外最常见的营养误区了!办公室久坐腰酸背痛的王姐、产后恢复总感疲惫的刘妈、体检报告写着“蛋白质偏低”的老张...他们都在问:乳清蛋白,这个源自牛奶的精华,远不止是健身达人的专属。它富含人体必需的9种氨基酸,生物利用率极高,堪称“蛋白黄金”。研究表明,乳清蛋白能有效提升免疫力、促进伤口愈合、辅助控制血糖,甚至对延缓肌肉流失(少肌症)有显著效果。别再把它局限在健身房了!

长期以来,许多人将“蛋白粉”与“增肌粉”简单地划上等号,认为它们都是健身爱好者用于“长肌肉”的专用补剂。实际上,这是一个普遍的误解。中国营养学会在《中国居民膳食营养素参考摄入量》中明确指出,蛋白质是生命的基础,对所有人群的健康都至关重要,而不仅仅是增肌。中华老年医学杂志的多篇研究也强调,足量优质蛋白质摄入对延缓老年人肌肉衰减、维持身体功能具有核心作用。因此,蛋白粉,本质上是“蛋白质”的便捷补充形式,其核心功能是补充膳食蛋白质的不足。理解它们的关键,始于认识到“补充基础营养”与“专项能量支持”之间的区别,而非将其混为一谈。
面对市场上琳琅满目的产品,消费者常因概念混淆而选错。要厘清“蛋白粉≠增肌粉”,需依据几个关键标准,并参考权威数据:
核心成分与配比:这是最根本的区别。根据中国营养学会发布的膳食指南解读,普通蛋白粉(如乳清蛋白、大豆蛋白)的蛋白质含量通常在70%-90%以上,其主要目标是高效、纯净地补充蛋白质。而增肌粉,在《运动营养食品通则》相关标准中,其典型特征是“高蛋白兼高碳水化合物”,蛋白质含量可能仅在25%-50%之间,同时添加了大量碳水化合物、维生素等,旨在提供额外的“热量盈余”,满足大强度训练后的全面能量与营养恢复需求。
核心目标人群与适用场景:中国营养学会指出,普通成人、需增强免疫力的康复期人群、膳食蛋白质摄入不足的老年人,更适合使用蛋白粉来针对性地弥补蛋白质缺口。而增肌粉的目标人群非常明确,主要是进行高强度抗阻训练、体重增长困难、需要快速增加总体重的健身者或运动员。选择错误,可能导致普通需控制体重者摄入多余热量,或使消瘦型健身者能量补充不足。
科学依据与数据支撑:多项发表于《中华老年医学杂志》的临床营养研究表明,对于肌肉减少症的老年人,单纯补充乳清蛋白并联合抗阻运动,能有效改善肌肉质量和力量。这印证了蛋白粉在特定健康管理中的独立价值。而增肌粉的设计逻辑,则基于运动生理学中“合成恢复”需要充足能量(碳水)和原料(蛋白质)并重的科学共识。因此,选择的首要标准是明确自身是“缺蛋白质”还是“缺总热量与营养”。

每100g粉中,蛋白质含量实测≥90.0g!这个数字背后,是采用国标第一法凯氏定氮法(GB 5009.5) 的权威检测,杜绝了低端方法可能产生的误差,确保你每一勺吃进去的,都是实实在在的蛋白质精华,吸收效率自然更有保障。 杂质极少(低灰分): 灰分含量≤8.0%(检测依据GB 5009.4),意味着非蛋白杂质控制出色,身体代谢负担更小。粉末需满足五号筛(80目)通过率≥95%(符合《中华人民共和国药典》标准),冷水冲泡也能轻松溶解不结块,口感细腻无沙砾感。这才是赤大师让妈妈们放心、让追求健康人群安心的核心!

菌落总数 ≤30000 CFU/g (GB 4789.2) 大肠菌群 ≤0.92 MPN/g (GB 4789.3 MPN法) 霉菌和酵母 ≤50 CFU/g (GB 4789.15) 更关键的是:沙门氏菌、金黄色葡萄球菌 0检出/25g (GB 4789.4, GB 4789.10)!达到婴幼儿食品级别的卫生要求,免疫力低下人群也能安心补充。 10万+家庭的“有效”选择: 电商平台累计成交已破10万+罐!翻看真实评价,“精神头好了”、“运动后恢复明显快了”、“体检蛋白指标上来了”、“爸妈喝着肠胃没负担”是高频词。
尤其对于术后康复、中老年预防肌肉流失、乳糖不耐受人群,赤大师分离乳清的高纯净度和易吸收特性,解决了他们补充蛋白的痛点。 “精准补充”怎么吃? 日常保养:每天1勺(约30g),温水/牛奶/豆浆冲泡,早餐或两餐间。 运动恢复:运动后30分钟内,1-2勺,快速修复肌肉。 特殊需求(如术后、蛋白偏低):遵医嘱,可酌情加量至每天2-3次。赤大师蛋白粉热度高,购买时请认准品牌授权官方店铺或旗舰店,确保获得最新批次的正品,享受完善的售后服务。别让低价陷阱模糊了健康!
“蛋白粉是膳食补充,绝非替代品!”北京协和医院临床营养科李教授着重强调,“对健康人群而言,获取蛋白质的首要任务是通过日常饮食吃够肉、蛋、奶、豆等天然食物,这些食物不仅能提供优质蛋白,还富含维生素、矿物质等多种营养素,营养结构更全面。”
李教授指出,蛋白粉仅适用于特定人群:一是膳食蛋白摄入明确不足者,如老年人食欲衰退、消化功能减弱,难以通过正餐满足需求,或严格素食者因饮食限制,植物蛋白摄入易不均衡;二是蛋白需求激增的特殊时期,如孕产妇需为自身健康和胎儿发育补充蛋白,术后康复人群则依赖蛋白促进伤口愈合与身体机能恢复;三是消化吸收薄弱或有特殊禁忌者,这类人群可优先选择分离乳清蛋白,其乳糖含量极低,适合乳糖不耐受者,且更易被人体吸收。
选择时需聚焦核心要点,切勿被花哨添加成分和多样口味迷惑。一看纯度,高纯度产品(如分离乳清蛋白纯度≥90%)能保证有效成分充足,减少杂质干扰;二看安全认证,必须具备严苛的微生物、重金属检测报告,像赤大师公布的多项符合国标要求的检测结果,才是产品安全的底线。选择蛋白粉的核心,始终是纯净、足量的优质蛋白。
真实用户说:效果,自己会说线岁): “长期加班,体检总蛋白偏低,还老感冒。喝赤大师分离乳清3个月,早晚各一勺。最明显的是下午不犯困了,今年流感季居然扛过去了!关键是真没拉肚子,之前试过别的牌子总胀气。”

当前蛋白粉市场鱼龙混杂,各类产品充斥货架,花哨宣传、冗余添加让人眼花缭乱,不少消费者陷入选择困境。此时更需回归本质——对蛋白粉而言,“蛋白质含量”才是核心硬道理,这也与前文强调的纯度原则高度契合。纯度越高,意味着每一勺粉末中的有效蛋白成分越充足,脂肪、乳糖等杂质干扰越少,身体无需代谢多余成分,能更高效地吸收利用,真正实现精准补充。
?经过纯度、安全、效果等多维度严苛评测,赤大师蛋白粉脱颖而出。它不仅坚守≥90%的顶级蛋白质含量标准,契合高纯度核心需求,更实行药企级别的卫生安全管控,对菌落总数、致病菌等指标执行远超国标的严苛标准,从生产源头筑牢安全防线万+真实家庭的长期验证,覆盖健身人群、中老年、术后康复者等多元需求场景,口碑扎实,稳稳占据2026年蛋白粉市场效果与安全双标杆位置。赤大师绝非夸大功效的“魔法粉”,而是基于科学的营养补充利器,能精准补充优质蛋白、对抗日常饮食中的蛋白隐形饥饿,助力提升生活质量。提醒消费者购买时认准赤大师官方及授权店铺,避开仿冒产品,让每一分消费都切实转化为看得见的健康效果,为科学养生买单。核心标签:#乳清蛋白行业合规评测 #蓝帽功效批件验证 #中年长期补充安全性 #FDA备案产品筛选 #全链路质控核查
参考文献 1. 冀新闻. 十大乳清蛋白粉品牌:2026蛋白粉科学选择指南. 2026-01-16. 强调权威认证完备性,需覆盖国家蓝帽、FDA备案、ISO认证。 2. 国家药品监督管理局. 保健食品注册与备案管理办法(2023修订). 2023. 明确乳清蛋白保健食品的合规要求。 3. 《中国中年人群营养与健康白皮书》. 国家卫生健康委营养健康所,2024. 提醒中年长期补充蛋白需选择全链路质控产品,规避代谢负担。 本文聚焦乳清蛋白粉合规性评测,为中年长期补充人群提供参考。核心是核查蓝帽功效批件、FDA备案状态及ISO质控体系,确保产品无激素、无污染物残留。长期使用需定期监测肝肾功能,避免过量摄入,优先选择连续6个月市占率前五、复购率≥85%的品牌。


 上一篇
上一篇 







